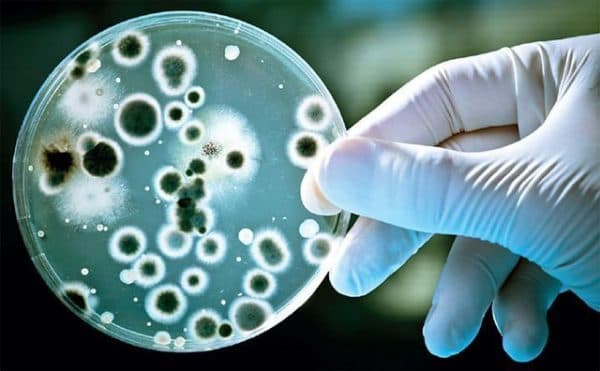
Xét nghiệm nuôi cấy xác định vi khuẩn Hp kháng thuốc giúp các bác sĩ đưa ra phác đồ hiệu quả cho từng bệnh nhân

Giải pháp chấm dứt sự hoành hành của vi khuẩn HP dạ dày
Viêm loét dạ dày tái đi tái lại, đâu là nguyên nhân?

- Vi khuẩn Hp có thể là nguyên nhân khiến viêm dạ dày tái phát nhiều lần
Cách đây 5 năm anh Nguyễn Hoàng (47 tuổi – Hà Nội) cảm thấy đau tức vùng thượng vị, buồn nôn, ăn uống không ngon miệng,… Anh đi khám thì được bác sĩ chẩn đoán là viêm dạ dày, dương tính với vi khuẩn Hp. Kể từ đó anh chạy chữa khắp nơi nhưng không khỏi: “Thời gian đầu uống thuốc thấy đỡ nên tôi dừng lại. Sau đó bệnh tái phát, tôi mua lại đơn thuốc đó. 2,3 lần như vậy cuối cùng lại trở về con số 0, thậm chí còn nặng hơn cả ban đầu”, anh Hoàng chia sẻ.
Sau khi thăm khám, nắm được tình trạng cũng như tiểu sử bệnh của anh, bác sĩ nghi ngờ vi khuẩn Hp có trong dạ dày của anh Hoàng đã kháng thuốc: “Vi khuẩn Hp rất khó điều trị vì khả năng kháng thuốc cực mạnh của nó. Anh Hoàng dương tính với vi khuẩn Hp, không tuân thủ phác đồ của bác sĩ nên rất có khả năng Hp có trong dạ dày của anh Hoàng đã kháng thuốc”, TS. BS CKII Nội tiêu hóa., Thầy thuốc ưu tú Phạm Thị Bình – Chuyên khoa tiêu hóa Bệnh viện ĐKQT Thu Cúc chia sẻ.
“Vi khuẩn Hp dạ dày ngày càng nguy hiểm và khó trị, khi vi khuẩn Hp kháng thuốc sẽ khiến bệnh tái phát nhiều lần, từ đó người bệnh có nguy cơ phải đối mặt với những vấn đề sức khỏe rất đáng lo ngại”, bác sĩ Bình cho biết thêm.
Vi khuẩn Hp là nguyên nhân chính gây bệnh viêm dạ dày cấp và mạn tính, loét dạ dày tá tràng và ung thư dạ dày. Theo thống kê, 75% đến 85% bệnh nhân mắc bệnh loét dạ dày – tá tràng dương tính với vi khuẩn Hp. Trong biến chứng thủng do loét dạ dày tá tràng thì sự hiện diện của vi khuẩn này chiếm đến 80% – 95% trường hợp. Điều đáng nói, đây là loại vi khuẩn rất khó điều trị, tỷ lệ kháng thuốc kháng sinh của chúng đã lên đến 55%.
Làm thế nào để loại bỏ vi khuẩn Hp hữu hiệu?
Theo các chuyên gia y tế, để loại bỏ vi khuẩn Hp hiệu quả cần nhiều yếu tố:
Xét nghiệm xác định vi khuẩn Hp kháng thuốc
- Xét nghiệm nuôi cấy xác định vi khuẩn Hp kháng thuốc giúp các bác sĩ đưa ra phác đồ hiệu quả cho từng bệnh nhân
Xét nghiệm xác định vi khuẩn Hp kháng thuốc giúp bác sĩ xác định vi khuẩn có trong dạ dày của bạn kháng với loại kháng sinh nào và nhạy với kháng sinh nào từ đó đưa ra phác đồ phù hợp cho từng người. Để thực hiện xét nghiệm này, bạn sẽ cần tiến hành nội soi dạ dày và lấy sinh thiết. Mẫu tế bào được lấy từ trong chính dạ dày này của bạn sẽ được nuôi cấy trong môi trường đặc biệt để xác định đó là loại vi khuẩn Hp nào. Đây là xét nghiệm tân tiến, quá trình nuôi cấy khá phức tạp, đòi hỏi thiết bị y tế hiện đại, bác sĩ có chuyên môn vững vàng, cũng chính vì thế mà không phải cơ sở y tế nào cũng làm được xét nghiệm này. Một trong số ít những cơ sở triển khai điều trị vi khuẩn HP kháng thuốc bằng việc nuôi cấy vi khuẩn là Bệnh viện Đa khoa Quốc tế Thu Cúc.
Phác đồ điều trị đặc hiệu
Trong trường hợp vi khuẩn Hp kháng thuốc, người bệnh phải ngừng ngay phác đồ cũ, thay thế bằng một phác đồ khác. Dựa vào kết quả xét nghiệm vi khuẩn Hp kháng thuốc bác sĩ sẽ xác định được vi khuẩn đó nhạy với kháng sinh nào và kháng loại kháng sinh nào để xây dựng phác đồ đặc hiệu. Người bệnh cần tuyệt đối tuân thủ phác đồ này trong 14 ngày, không tự ý dừng thuốc, cần uống đúng và đủ liều lượng. Sau 14 ngày, người bệnh quay lại kiểm tra để đảm bảo rằng vi khuẩn Hp đã được đẩy lùi.
Bác sĩ giỏi – “chìa khóa” triển khai phác đồ điều trị hiệu quả
-
TS. BS CKII Nội tiêu hóa., Thầy thuốc ưu tú Phạm Thị Bình –Bệnh viện ĐKQT Thu Cúc là chuyên gia điều trị vi khuẩn Hp hiệu quả
Để xây dựng được phác đồ hiệu quả thì bác sĩ có kiến thức chuyên môn vững vàng, được tích lũy trong nhiều năm là điều vô cùng quan trọng.
Bệnh viện Thu Cúc hội tụ đội ngũ chuyên môn giỏi, nhiều năm kinh nghiệm như TS. BS CKII Nội tiêu hóa., Thầy thuốc ưu tú Phạm Thị Bình. Bác sĩ Bình đã dành nhiều năm dày công nghiên cứu về vi khuẩn Hp, có kiến thức chuyên môn sâu rộng vì thế luôn đưa ra phác đồ chính xác nhất.
Không những vậy, tất cả các các bác sĩ tại Bệnh viện Thu Cúc đều được đào tạo chuyên sâu, có kiến thức vững vàng, phác đồ điều trị vi khuẩn Hp được áp dụng tại Thu Cúc được tất cả các bác sĩ áp dụng hiệu quả ở cả Bệnh viện ĐKQT Thu Cúc (286 Thụy Khuê, Tây Hồ, Hà Nội) và Phòng khám ĐKQT Thu Cúc (216 Trần Duy Hưng, Cầu Giấy, Hà Nội).
Được thực hiện xét nghiệm nuôi cấy vi khuẩn Hp và tuân thủ tuyệt đối yêu cầu của bác sĩ, sau 14 ngày anh Hoàng đã loại bỏ được Hp – điều mà suốt 5 năm anh không làm được, từ đó bệnh viêm loét dạ dày của anh cũng được thuyên giảm. Chia sẻ về điều này, anh Hoàng vui mừng: “Thật là khó tin, sau khi bác sĩ nói vi khuẩn Hp của tôi đã kháng thuốc tôi vô cùng lo lắng vì biết rằng việc điều trị chúng đã khó khăn nay lại càng khó khăn hơn. Nhưng điều tôi không ngờ là tôi đã khỏi vi khuẩn Hp chỉ trong 14 ngày. Đúng là bác sĩ giỏi, công nghệ hiện đại và nhận được những lời tư vấn, dặn dò kỹ của bác sĩ tại Bệnh viện Thu Cúc càng làm tôi ý thức và nghiêm túc thực hiện nên mới có kết quả tốt như vậy”.












